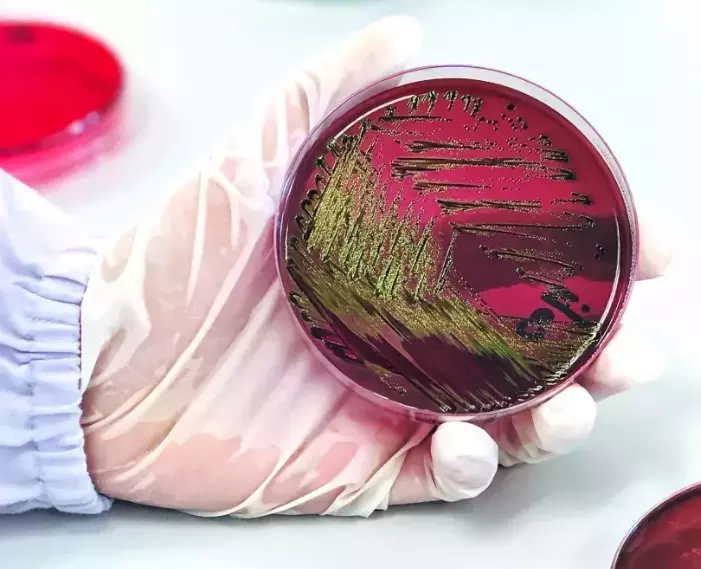
Cultura de Célula

A água ultrapura representa um dos elementos mais críticos para o sucesso de protocolos microbiológicos em laboratórios modernos. Sua pureza não apenas garante a integridade dos resultados, mas também assegura a reprodutibilidade dos experimentos e a confiabilidade dos dados gerados. No contexto da microbiologia, onde a precisão é fundamental, a qualidade da água pode determinar o sucesso ou fracasso de uma pesquisa.
A Importância Crítica da Água Ultrapura em Laboratórios de Microbiologia

Em laboratórios de microbiologia, a água atua como base para praticamente todos os protocolos, desde a preparação de meios de cultura até a diluição de reagentes e lavagem de equipamentos. Contaminantes presentes na água comum, como íons metálicos, matéria orgânica, endotoxinas e microorganismos, podem interferir significativamente nos resultados experimentais, levando a dados imprecisos e conclusões errôneas. Por que você deve se preocupar com as impurezas da água? é uma questão fundamental que todo laboratório deve considerar.
A presença de contaminantes pode provocar diversos problemas: crescimento microbiano indesejado, inibição de culturas específicas, alteração no pH dos meios, formação de precipitados e interferência em reações enzimáticas. Estes desafios tornam evidente a necessidade de sistemas de purificação de água altamente eficientes e confiáveis. Para compreender melhor os 5 riscos que todo cientista deve enfrentar se não utiliza água reagente, é essencial conhecer as tecnologias de purificação disponíveis.
A Veolia, líder mundial em soluções de tratamento de água, desenvolve tecnologias avançadas que atendem às demandas mais rigorosas de laboratórios microbiológicos, garantindo água de qualidade superior para aplicações científicas críticas.
Água Ultrapura em Meios de Cultura Seletivos
A preparação de meios de cultura seletivos demanda água de pureza, pois estes meios são formulados para permitir o crescimento de microorganismos específicos enquanto inibem outros. A presença de contaminantes na água pode alterar drasticamente a seletividade destes meios, comprometendo a eficácia dos protocolos microbiológicos.
Impurezas como íons metálicos podem atuar como cofatores enzimáticos não desejados, alterando o metabolismo microbiano e afetando a seletividade dos meios. Compostos orgânicos presentes na água podem servir como fontes alternativas de carbono, permitindo o crescimento de microorganismos que deveriam ser inibidos. Além disso, variações no pH causadas por contaminantes podem alterar a eficácia de indicadores e agentes seletivos.
Os requisitos específicos para meios de cultura seletivos incluem resistividade superior a 18 MΩ·cm, teor de carbono orgânico total (TOC) inferior a 10 ppb, e contagem bacteriana inferior a 10 CFU/mL. Para ser classificada como ultrapura, a água não deve conter endotoxinas detectáveis, tipicamente mantendo níveis inferiores a 0,03 EU/mL. Estes parâmetros garantem que o meio mantenha suas características seletivas originais.
Laboratórios microbiológicos que implementaram sistemas Veolia relatam melhorias significativas na reprodutibilidade de resultados, redução de contaminações cruzadas e maior confiabilidade em protocolos de identificação microbiana. A consistência na qualidade da água traduz-se diretamente em maior precisão diagnóstica e eficiência operacional. Para laboratórios que buscam garantir água ultrapura para sua aplicação de laboratório, a escolha do sistema adequado é fundamental.
Ultrafiltração: A Tecnologia Mais Eficaz para Remoção de Endotoxinas em Água para Laboratórios Microbiológicos
As endotoxinas, também conhecidas como lipopolissacarídeos (LPS), são componentes da parede celular de bactérias gram-negativas que podem causar respostas inflamatórias severas em organismos vivos. Em estudos microbiológicos, a presença de endotoxinas pode interferir em ensaios de citotoxicidade, culturas celulares e testes de biocompatibilidade, gerando resultados falsos-positivos ou mascarando efeitos reais.
A ultrafiltração emerge como a tecnologia mais eficaz para a remoção de endotoxinas da água. Este processo utiliza membranas com poros de tamanho molecular definido (tipicamente 1-10 kDa) que retêm fisicamente as endotoxinas enquanto permitem a passagem de moléculas de água e íons pequenos.
Os sistemas de ultrafiltração da Veolia incorporam membranas de alta performance com características específicas: distribuição homogênea de poros, alta resistência à pressão, baixa tendência ao fouling e capacidade de regeneração. Estas membranas são capazes de reduzir os níveis de endotoxinas para menos de 0,001 EU/mL, atendendo aos requisitos mais rigorosos de laboratórios microbiológicos.
Comparado a outros métodos de eliminação de endotoxinas, como adsorção em carvão ativado ou tratamento térmico, a ultrafiltração oferece vantagens significativas: remoção física e definitiva das endotoxinas, não introdução de contaminantes secundários, operação contínua e eficiência consistente independente da carga inicial de endotoxinas.
Água Ultrapura Estéril e Apirogênica para Cultura de Células
As culturas celulares representam uma das aplicações mais sensíveis da microbiologia, exigindo condições extremamente controladas para manter a viabilidade e funcionalidade celular. A água utilizada nestes protocolos deve atender a requisitos rigorosos de esterilidade e ausência de pirogênios para evitar comprometer a integridade das culturas.
A esterilidade da água é fundamental para prevenir contaminações microbianas que podem rapidamente superar as culturas celulares, alterando o pH do meio, consumindo nutrientes essenciais e produzindo metabólitos tóxicos. A ausência de pirogênios é igualmente crítica, pois estas substâncias podem induzir respostas inflamatórias nas células, alterando seu comportamento e comprometendo a validade dos experimentos.
Contaminantes presentes na água podem afetar a viabilidade celular de diversas formas: íons metálicos podem causar estresse oxidativo, compostos orgânicos podem interferir no metabolismo celular, e endotoxinas podem ativar vias inflamatórias. Estes efeitos podem ser sutis, manifestando-se apenas após várias passagens celulares, tornando a detecção precoce desafiadora.
As soluções Veolia para cultura celular incluem sistemas integrados que combinam múltiplas tecnologias de purificação: troca iônica, adsorção, ultrafiltração e esterilização por UV. Esta abordagem multicamada garante a remoção eficaz de todos os tipos de contaminantes, produzindo água de alta pureza: essencial para meios de cultura e soluções em laboratório. Desafios nos laboratórios farmacêuticos: garantir água pura destacam a importância de sistemas confiáveis para aplicações críticas.
Água Ultrapura nos Protocolos de Biomoléculas
As técnicas moleculares, como PCR (Reação em Cadeia da Polimerase), sequenciamento de DNA e análise de RNA, representam ferramentas fundamentais da microbiologia moderna. Estas técnicas dependem da pureza da água utilizada, pois contaminantes podem interferir diretamente nas reações enzimáticas, degradar biomoléculas ou gerar sinais falsos.
Na PCR, a presença de íons metálicos pode inibir significativamente a atividade da DNA polimerase. Estudos científicos demonstram que metais como zinco, estanho, ferro(II) e cobre apresentam os efeitos inibitórios mais fortes. Compostos orgânicos podem atuar como moldes inespecíficos, gerando produtos de amplificação indesejados e reduzindo a eficiência da reação em até 50% em alguns casos.
As impurezas afetam a integridade das biomoléculas através de diversos mecanismos: hidrólise catalisada por íons metálicos, oxidação por radicais livres, desnaturação por detergentes residuais e degradação enzimática por nucleases e proteases contaminantes. Estes efeitos podem ser cumulativos, tornando-se mais pronunciados em protocolos de longa duração ou que envolvem múltiplas etapas.
Os padrões de água para trabalho com proteínas, DNA e RNA são especialmente rigorosos: resistividade mínima de 18,2 MΩ·cm, TOC inferior a 5 ppb, ausência de nucleases e proteases, e níveis de endotoxinas inferiores a 0,001 EU/mL. Para técnicas de PCR, recomenda-se água com resistividade de 18,2 MΩ·cm e TOC menor que 5 ppb para garantir ausência de íons metálicos e compostos orgânicos que possam interferir na atividade da polimerase. Estes parâmetros garantem que a água não interfira nas biomoléculas nem nas reações enzimáticas.
As tecnologias Veolia específicas para aplicações biomoleculares incluem sistemas de ultrafiltração de alta eficiência, cartuchos de troca iônica especializados, lâmpadas UV de alta intensidade e filtros de membrana com retenção absoluta. Estas tecnologias de purificação que garantem a qualidade da água nos laboratórios trabalham em sinergia para produzir água com pureza excepcional, adequada para as aplicações biomoleculares mais sensíveis. Os laboratórios que enfrentam os 4 desafios enfrentados pela pesquisa genética e genômica encontram nas soluções Veolia a resposta para suas necessidades específicas.
Soluções Veolia para Laboratórios Microbiológicos

A linha PURELAB ELGA representa a tecnologia mais avançada em sistemas de purificação de água para aplicações laboratoriais, integrando múltiplas tecnologias de purificação em configurações otimizadas que combinam inovação, design inteligente e desempenho excepcional. Desenvolvidos para atender desde análises microbiológicas de rotina até pesquisas especializadas de alta complexidade, estes sistemas garantem os mais rigorosos padrões de qualidade exigidos pela pesquisa científica moderna.
As características técnicas dos sistemas PURELAB incluem: tecnologia de troca iônica com resinas de alta capacidade, ultrafiltração com membranas de performance superior, esterilização UV com lâmpadas de alta intensidade, monitoramento contínuo da qualidade da água e sistemas de controle automatizados. Estas características garantem produção consistente de água ultrapura com qualidade superior.
As capacidades dos sistemas variam desde unidades compactas para laboratórios pequenos até sistemas centralizados para instalações de grande porte. Todos os sistemas oferecem flexibilidade operacional, permitindo ajustes conforme as necessidades específicas de cada aplicação microbiológica.
As opções de personalização incluem configurações de pontos de uso múltiplos, sistemas de distribuição com loops de recirculação, tanques de armazenamento com atmosfera inerte e sistemas de monitoramento remoto. Esta flexibilidade permite que cada laboratório configure um sistema perfeitamente adequado às suas necessidades específicas.
O serviço técnico da Veolia inclui instalação profissional, treinamento de operadores, manutenção preventiva programada e suporte técnico especializado. Este suporte abrangente garante operação confiável e performance consistente ao longo de toda a vida útil do sistema. A importância de ter um parceiro para os serviços de água do seu laboratório vai além do fornecimento de equipamentos, incluindo suporte contínuo e expertise técnica. Porque escolher a ELGA como seu parceiro de laboratório? Esta questão é fundamental para laboratórios que buscam excelência operacional.
Perspectivas Futuras e Inovação Contínua
As tendências em purificação de água para microbiologia apontam para sistemas cada vez mais inteligentes e eficientes. O desenvolvimento de tecnologias de monitoramento em tempo real, algoritmos de otimização automática e interfaces de usuário intuitivas está revolucionando a operação de laboratórios microbiológicos.
A integração de tecnologias de Internet das Coisas (IoT) permite monitoramento remoto e diagnóstico preditivo, reduzindo significativamente os custos operacionais e aumentando a confiabilidade dos sistemas. A análise de dados em tempo real possibilita otimizações automáticas que maximizam a eficiência e minimizam o consumo de recursos. Para laboratórios interessados em aumentar o tempo de vida de seus consumíveis e reduzir o custo operacional do seus sistema de purificação, essas inovações representam oportunidades significativas de otimização.
O compromisso da Veolia com a inovação contínua reflete-se no investimento constante em pesquisa e desenvolvimento, parcerias com instituições acadêmicas de renome e colaboração próxima com laboratórios líderes mundiais. Este compromisso assegura que as soluções Veolia permaneçam na vanguarda tecnológica, atendendo às necessidades evolutivas da microbiologia moderna.
Em resumo, a água ultrapura representa um elemento fundamental para o sucesso de protocolos microbiológicos modernos. Sua pureza excepcional garante resultados precisos, reprodutibilidade experimental e confiabilidade científica. As tecnologias avançadas da Veolia oferecem soluções completas que atendem às demandas mais rigorosas de laboratórios microbiológicos, contribuindo significativamente para o avanço da ciência e da tecnologia.

Precisa melhorar a qualidade e reprodutibilidade dos seus protocolos microbiológicos?
Entre em contato com nossos especialistas para uma avaliação personalizada das suas necessidades de água ultrapura. Solicite uma demonstração gratuita dos nossos sistemas PURELAB para laboratórios de microbiologia.
Quer receber conteúdos, estudos exclusivos, convites para eventos e muito mais?
Clique aqui e se inscreva!
Continue navegando...
Soluções de purificação de água de laboratório
Descubra as soluções de purificação de água ELGA para laboratórios. Desde água ultrapura Tipo I até água Tipo III, temos o sistema ideal para suas necessidades de pesquisa.
Aplicações Laboratoriais
Descubra a solução perfeita para sua aplicação. Garanta a pureza ideal para cada protocolo específico, desde análises ultrassensíveis até procedimentos rotineiros.
Lab Experience
Explore conteúdo especializado sobre água ultrapura, técnicas analíticas e protocolos laboratoriais. Descubra as melhores práticas em purificação e soluções personalizadas para otimizar a rotina do seu laboratório.
Fale com um especialista
Entre em contato com um de nossos especialistas, invista em soluções inteligentes de purificação de água de laboratório.






